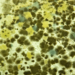
Prof. Dr. Ahmet Akçay : Küf sporlarına dikkat!

Sokak köpeklerinin harita üzerinde yerini gösteren internet uygulaması Havrita, hayvanlara karşı işlenen suçları yeniden gündeme getirdi. Peki hayvanlara zarar vermenin cezası nedir? Böyle bir durumla karşılaşan insanlar ne yapmalı? Hayvanın sahipsiz olması cezayı etkiler mi? Bir hayvanın verdiği zarardan dolayı sahibine ceza kesilir mi? Merak edilenleri Avukat Cem Duman yanıtladı.
Hapis cezası alabilir
Hayvanlara karşı işlenen suçlara verilen cezalar hakkında bilgi veren Avukat Cem Duman, “Hayvanları Koruma Kanununun 28/A maddesi uyarınca, bir ev hayvanını veya evcil hayvanı kasten öldüren kişi altı aydan dört yıla kadar hapis cezası ile; bir ev hayvanına veya evcil hayvana işkence eden veya acımasız ve zalimce muamelede bulunan kişi altı aydan üç yıla kadar hapis cezası ile; hayvanları dövüştüren kişi üç aydan iki yıla kadar hapis veya adli para cezası ile; hayvanlara cinsel saldırıda bulunan veya tecavüz eden kişi altı aydan üç yıla kadar hapis ve yüz günden az olmamak üzere adli para cezası ile cezalandırılır. Suçların birden fazla hayvana karşı işlenmesi halinde ise verilecek ceza yarı oranında arttırılacaktır. Ayrıca hayvanlara karşı işlenen suçun türüne göre Hayvanları Koruma Kanununun 28. maddesi uyarınca suçu işleyen kişi, 500 TL’den 35.000 TL’ye kadar idari para cezası ile cezalandırılabilecektir” dedi.
Sokak hayvanlarını da kapsıyor
Hayvanın sahipli ya da sahipsiz olmasının suçlu kişinin aldığı cezada yarattığı fark hakkında ise Duman, “Hayvanları Koruma Kanununun 28/A maddesinin gerekçesinde ev hayvanı; ‘kişiler tarafından özellikle evde, iş yerlerinde ya da arazisinde özel ilgi ve refakat amacıyla muhafaza edilen, bakımı ve sorumluluğu sahiplerince üstlenilen her türlü hayvan’ olarak tanımlanırken evcil hayvan; ‘insan tarafından kültüre alınmış ve eğitilmiş hayvanlar’ şeklinde tanımlanmıştır. Ayrıca madde gerekçesinde kedi veya köpek gibi hayvanların sahipsiz olsa dahi insan tarafından kültüre alınmış hayvan olduğu kabul edilerek evcil hayvan statüsünde olduğu yer almaktadırlar. Dolayısıyla verilecek cezada bir fark olmayacaktır” diye konuştu.
‘İhbarda bulunun’
Hayvana karşı işlenen bir suça şahit olunması durumunda izlenmesi gereken yol hakkında da bilgi veren Duman, “Şahit olunması halinde Hayvanları Koruma Kanununun aradığı suçüstü halinin varlığı kabul edilerek polis, jandarma veya Cumhuriyet Başsavcılığına ihbarda bulunarak şüpheli hakkında soruşturma işlemlerinin başlaması sağlanabilecektir” ifadelerini kullandı.
Sahibine ceza kesilir
Peki, bir hayvan insanlara zarar verirse sahibine ceza kesilir mi? Konuyla ilgili Cem Duman, “Hayvanın zarar vermesi halinde, zarar gören zararını hayvanın bakım ve gözetimini üstlenen sahibinden TBK madde 67 doğrultusunda talep edebilecektir. Ancak hayvanın bakım ve gözetimini üstlenen sahibi zararın meydana gelmemesi için gerekli özeni göstermiş ise zarardan sorumlu olmayacaktır. Ayrıca bakım ve gözetimi altında bulunan hayvanı başkalarının hayatı veya sağlığı açısından tehlike yaratacak şekilde serbest bırakan yahut kontrol altına alınması konusunda ihmal gösteren kişi TCK madde 177 doğrultusunda 6 aya kadar hapis veya adli para cezası ile cezalandırılabilecektir” dedi.
‘Ceza artırılmalı’
Hayvanlara karşı işlenen suç sayısının her geçen gün arttığını kaydeden Duman şunları söyledi: “İlgili kanunlarla yapılan cezai yaptırımlar yetersiz kalmakta ve cezalandırmanın amaçlarından birisi olan caydırıcılığı sağlamamaktadır. Dolayısıyla hayvanlara karşı işlenen suçlarda hapis cezası sürelerinin arttırılmasına yönelik düzenleme yapılmasının elzem olduğu kanaatindeyiz.”